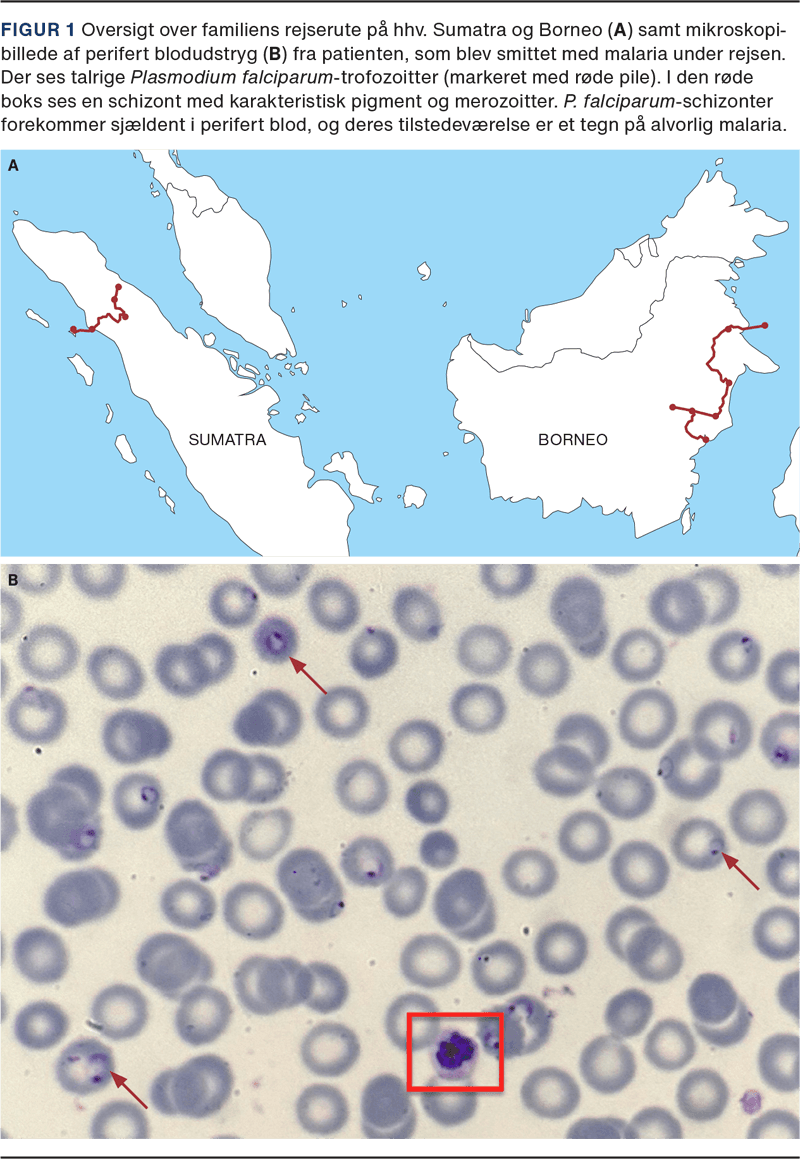

Cerebral malaria efter rejse til Indonesien

Katrine Kure Pollstergaard1, Lasse S. Vestergaard2, Huma Aftab3 & Anja Poulsen1
Malaria er fortsat en udbredt sygdom på globalt plan, og siden 2020 er der flere steder observeret en stigning i antallet af tilfælde, især i Afrika. I 2023 blev der estimeret 263 millioner tilfælde og 597.000 dødsfald [1]. Sygdommens sværhedsgrad afhænger bl.a. af patientens immunstatus, hvilket gør rejsende fra ikkeendemiske lande særligt udsatte for at udvikle alvorlig malaria [2]. Hurtig diagnostik og behandling er afgørende. [3]
Kendskab til aktuel geografisk udbredelse og lokal transmissionsintensitet af malaria er vigtig for korrekt rådgivning som profylakse. Selv om størstedelen af tilfældene findes i Afrika, er der fortsat risiko i andre regioner. I store dele af Asien inkl. Indonesien er forekomsten generelt lav, men enkelte områder kan have en midlertidig højere forekomst og lokale udbrud, typisk i regnsæsonen [4].
Sygehistorie
En 11-årig dreng blev akut indlagt på børneafdelingen efter syv dages influenzalignende symptomer med feber, myalgi, opkastninger og diarré. Natten før udviklede han ikterus. Familien var to uger forinden hjemvendt fra en måneds rejse i Indonesien. Først på Borneo og de sidste tolv dage var de på Sumatra, hvor malariasmitten sandsynligvis er sket (Figur 1). Forud for rejsen havde familien modtaget rejserådgivning og rejsevacciner, men var ikke informeret om risikoen for malaria. De havde derfor ikke haft fokus på myggestiksprofylakse, og de var heller ikke orienteret om forholdsregler ved feber.
Tre dage før indlæggelsen blev patienten set hos egen læge, hvor der blev podet for influenza efter samråd med hospitalslæge. Man valgte at afvente svaret herpå, før man tog stilling til eventuelle malariaundersøgelser, på trods af den oplyste rejseanamnese. Ved ankomst var patienten afkræftet, febril (38,9 °C), takykardi (puls 130) og ikterisk med påvirket bevidsthedsniveau, Glasgow Coma Scale (GCS) 13-14. En hurtigtest First Response Malaria Ag. pLDH/HRP2 Combo Card Test var positiv for Plasmodium-antigener, og blodudstryg bekræftede Plasmodium falciparum med en parasitæmigrad på 8,5%. Ved mikroskopi af blodudstryg blev der påvist aseksuelle former i alle stadier samt pigment i polymorfkernede leukocytter og i schizonter – se Figur 1. Patienten havde kompliceret malaria [2] med hæmolyse, trombocytopeni, nyre- og leverpåvirkning (kreatinin 75 μmol/l og ALAT 176 U/l), CRP på 293 mg/l samt metabolisk acidose. Behandlingen blev straks iværksat med i.v.-artesunat.
Kort efter indlæggelsen blev patienten tiltagende bevidsthedspåvirket, (GCS 6), og han blev intuberet. Der var stadig hæmolyse, udtalt hæmoglobinuri (blackwater fever), og der tilkom generaliserede toniske kramper. Efter tre dages malariabehandling og intensiv understøttende behandling blev patienten ekstuberet, og i de følgende dage normaliseredes lever- og nyrefunktionen og GCS steg til 15.
Der blev givet i.v.-artesunat i fire døgn. På anden dag faldt parasitæmigraden til 2% og tredje dag til < 0,1%. Fra femte dag blev givet atovaquon/proguanil peroralt i yderligere tre dage. Malariamikroskopi forblev negativ under opfølgning til dag 28. Han havde transfusionsbehov på sjette indlæggelsesdag og blev udskrevet efter 13 dage. Ved opfølgning to uger efter udskrivelse var hæmoglobin atter stigende, og en neuropsykologisk vurdering efter én måned viste ingen kognitive sequelae.
Denne kasuistik understreger den afgørende betydning af korrekt rejsemedicinsk rådgivning om malaria og tidlig diagnostik ved febersygdom efter ophold i malariaendemiske områder. Statens Serum Institut anbefaler generelt myggestiksprofylakse ved rejser til Sydøstasien, hvorimod kemoprofylakse i de fleste områder ikke længere anbefales rutinemæssigt på grund af den lave malariarisiko, som dog ikke er helt fraværende. I vores konkrete tilfælde blev patienten og dennes familie imidlertid ikke som del af den rejsemedicinske rådgivning informeret om malariarisikoen og nødvendigheden af malariaprofylakse forud for rejsen, og ej heller om vigtigheden af akut malariaundersøgelse ved feber og influenzalignende symptomer under og efter rejsen. Symptomerne blev initialt tolket som influenza, og man undlod undersøgelse for malaria, hvilket medførte diagnostisk forsinkelse og dermed forsinket start af malariabehandling, hvilket var medvirkende til, at patienten udviklede en alvorlig og kompliceret malariasygdom. Det er vigtigt at være opmærksom på, at risikoen for malaria i et lokalt område kan variere betydeligt fra år til år. Derfor bør alle patienter med feber og influenzalignende symptomer efter ophold i et malariaområde, herunder områder med formodet kun lav forekomst, undersøges for malaria uden forsinkelse, da hurtig start af behandlingen er afgørende for det kliniske forløb.
Korrespondance Katrine Kure Pollstergaard. E-mail: katrinekure@gmail.com
Antaget 16. september 2025
Publiceret på ugeskriftet.dk 1. december 2025
Interessekonflikter ingen. Alle forfattere har indsendt ICMJE Form for Disclosure of Potential Conflicts of Interest. Disse er tilgængelige sammen med artiklen på ugeskriftet.dk.
Referencer findes i artiklen publiceret på ugeskriftet.dk
Artikelreference Ugeskr Læger 2025;187:V05250380
doi 10.61409/V05250380
Open Access under Creative Commons License CC BY-NC-ND 4.0
A young Danish boy developed severe Plasmodium falciparum malaria after travel to Indonesia without malaria chemoprophylaxis or mosquito protection. Flu-like symptoms were misinterpreted as influenza, delaying diagnosis. He presented cerebral malaria and multiorgan failure requiring intensive care. Rapid treatment with IV artesunate led to full recovery. The case highlights the importance of correct travel advice, as well as early recognition of malaria symptoms and rapid malaria testing without delay after travel in a malaria endemic area, despite a low perceived local risk of malaria.